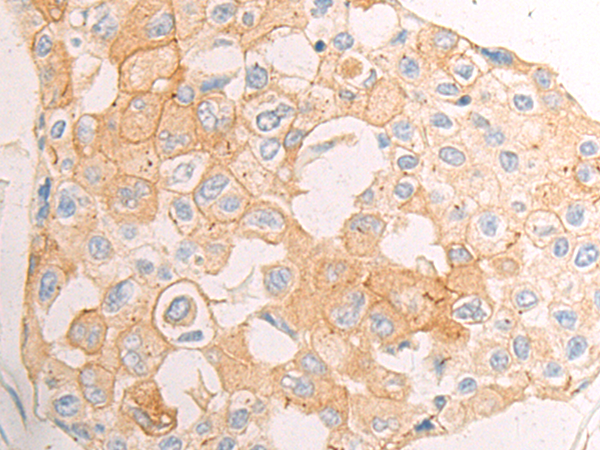
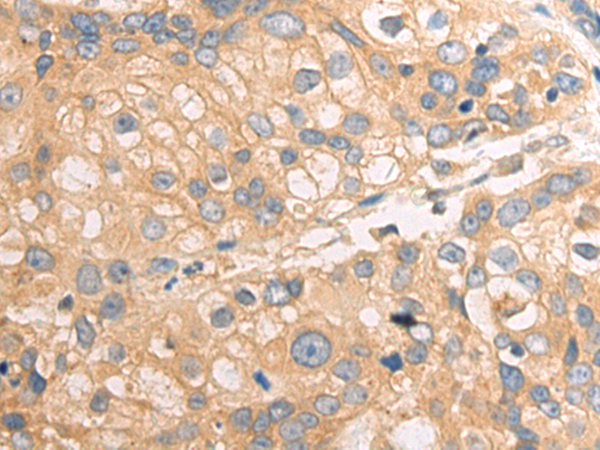

-
分类: 科研抗体货号: P00861别名: AAA; AAASb; GL003; ALADIN; ADRACALA; ADRACALIN应用: WB,IHC反应种属: Human, Mouse
-
分类: 科研抗体货号: P00859别名: ACDC; ADPN; APM1; APM-1; GBP28; ACRP30; ADIPQTL1应用: WB,IHC反应种属: Human, Mouse
-
分类: 科研抗体货号: P00911别名: ALS2CR11应用: WB反应种属: Human, Mouse
-
分类: 科研抗体货号: P00857别名: ASL; AMPS; ASASE应用: WB反应种属: Human, Mouse
-
分类: 科研抗体货号: P00964别名: AIP1; ARMER; SPG61; ARL6IP应用: WB,IHC反应种属: Human, Mouse
-
分类: 科研抗体货号: P00910别名: ALS2CR8; NYD-SP24应用: WB反应种属: Human
-
分类: 科研抗体货号: P00849别名: ADAM31; ADAM 21应用: IHC反应种属: Human
-
分类: 科研抗体货号: P00961别名: GIE2; ARL10B应用: WB,IHC反应种属: Human, Mouse
-
分类: 科研抗体货号: P00901别名: A1M; HCP; ITI; UTI; EDC1; HI30; ITIL; IATIL; ITILC应用: WB,IHC反应种属: Human
-
分类: 科研抗体货号: P00848别名: CSVP; TACE; NISBD; ADAM18; CD156B; NISBD1应用: WB,IHC反应种属: Human, Mouse, Rat

鄂公网安备42018502007531号
鄂公网安备42018502007531号

